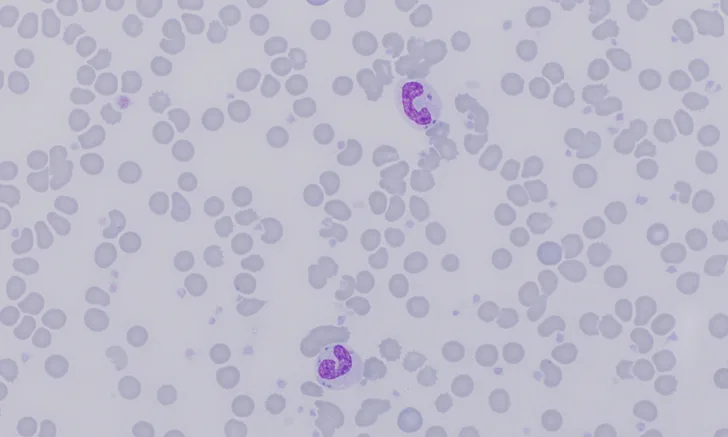
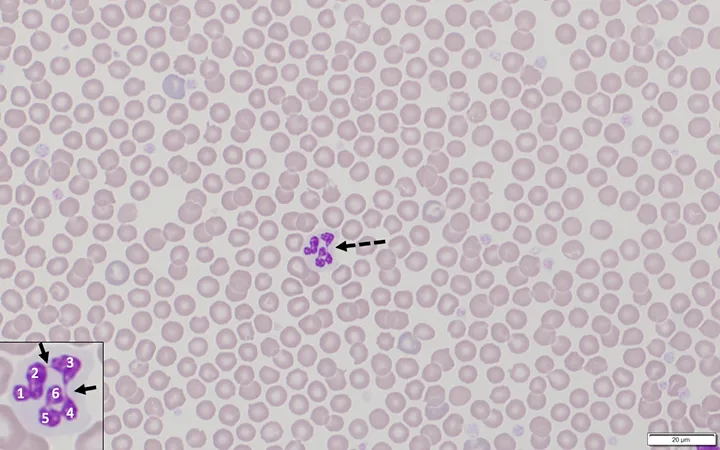
Blood smear showing numerous RBCs and a single hypersegmented neutrophil with inset showing details of the neutrophil.
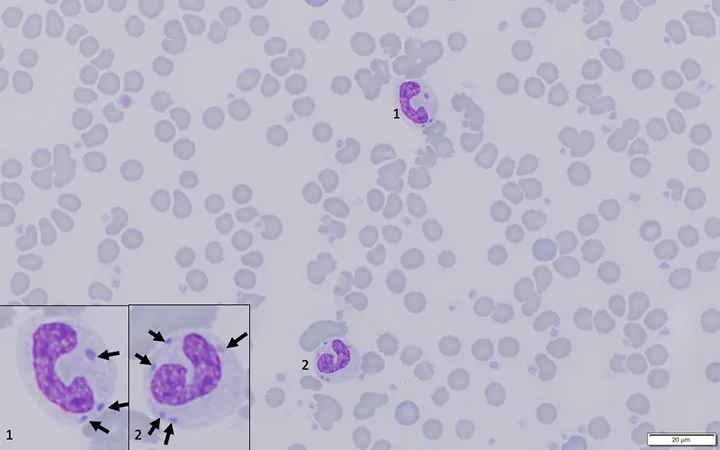
Blood smear showing numerous RBCs and 2 band neutrophils with inset showing details of the neutrophils.
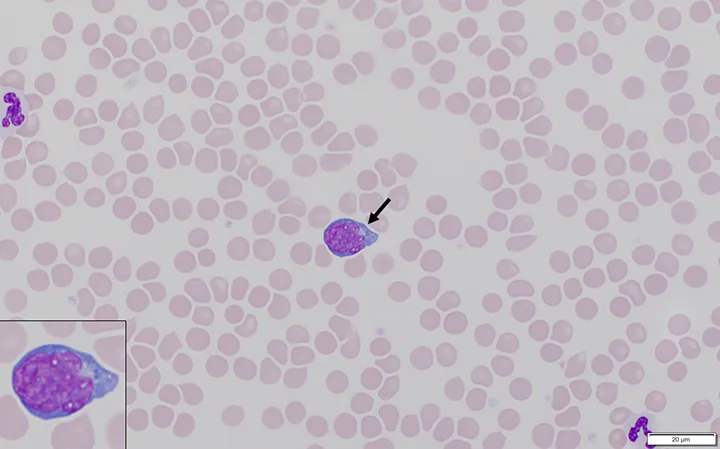
Blood smear showing numerous RBCs and arrow pointing to a large lymphocyte with inset showing details of the lymphocyte.

Top 5 Leukogram Patterns Associated With Abnormal Neutrophil Concentrations
Hao Shi, DVM, China Agricultural University, Beijing, China
Lisa M. Pohlman, DVM, MS, DACVP, Kansas State University
Changes in neutrophil concentrations are commonly identified on CBC, including those due to cells shifting between blood pools and as a result of increased bone marrow production or tissue consumption.
Neutrophils in the blood are distributed between 2 pools (ie, marginating, circulating) based on their location in the blood vessels. Free-flowing neutrophils are in the circulating pool. Neutrophils temporarily adhered to endothelial cells are in the marginating pool; binding occurs primarily in small capillaries and veins. After adherence to endothelial cells, neutrophils may enter the tissue or break loose and re-enter the circulating pool.
In most healthy mammal species, the WBC marginating:circulating pool ratio is 1:1, meaning there is an approximately equal number of neutrophils in each pool (Figure 1)1; however, in healthy cats, this ratio is 3:1, meaning there are 3 times as many segmented neutrophils in the marginating pool as in the circulating pool.1,2 Blood is collected from the circulating pool; thus, shifting of cells between pools can significantly affect CBC results.1,3
Following are, in the authors’ opinion, the 5 most common leukogram patterns related to abnormal neutrophil concentrations.

Neutrophils in the blood are distributed between the marginating and circulating pools. In healthy dogs, the marginating:circulating pool ratio is 1:1 (A). In cats, this ratio is 3:1 (B). Shifting of neutrophils between pools can result in significant changes in CBC results because blood is collected from the circulating pool.1 Image courtesy of Mallory Hoover
1. Corticosteroid/Stress Leukogram
The corticosteroid/stress leukogram pattern is characterized by leukocytosis due to mature (segmented) neutrophilia, lymphopenia, eosinopenia, and/or monocytosis (Table 1).1,3 These hematologic changes are a consequence of increased endogenous corticosteroids or administration of exogenous corticosteroids, which can have significant effects on WBC concentrations within a few hours of release or administration.3 There are many potential causes of increased endogenous glucocorticoid release, including prolonged emotional stress, trauma, pain, pyrexia, intense sustained exercise, and hyperadrenocorticism.
The corticosteroid/stress leukogram pattern should not be confused with excitement/physiologic leukocytosis caused by release of catecholamines during the fight or flight response.1
Mature neutrophilia seen with this leukogram pattern occurs primarily because of a shift of neutrophils from the marginating to the circulating pool due to corticosteroid-induced downregulation of adhesion molecules1 and increased release of mature neutrophils from the bone marrow storage pool.3 A slight increase in band neutrophils is possible because of increased release from the bone marrow.1
Corticosteroid/Stress Leukogram in a Dog Receiving Prednisone for Seasonal Allergies*
*Characterized by leukocytosis due to mature neutrophilia, no left shift, lymphopenia, and monocytosis
†Values outside the reference intervals are bold.
‡Percentage of cells identified on manual WBC differential; value used to calculate the absolute concentration (displayed in the result column)
Downregulation of adhesion molecules also results in decreased ability of neutrophils to migrate to tissues, thus increasing neutrophil circulation life span. Consequently, neutrophils age within circulation, and hypersegmented forms may be seen occasionally (Figure 2).1,4 Presence of hypersegmented neutrophils, however, is not required, and their absence does not rule out a corticosteroid/stress leukogram. Because of the 1:1 and 3:1 marginating:circulating pool ratios in dogs and cats, respectively, the magnitude of neutrophilia that results in cats during this response can be considerably higher than that observed in dogs.1,2,4
The characteristic lymphopenia is due to glucocorticoid-induced redistribution of lymphocytes to lymphoid organs and bone marrow, decreased proliferation and efflux of lymphocytes from lymph nodes, and dose- and species-dependent cytotoxic effects on lymphocytes. Severity and duration of lymphopenia are generally proportional to the dose and duration of increased corticosteroids. Presence of lymphopenia can help differentiate a corticosteroid/stress leukogram from an excitement/physiologic leukocytosis.1
Stress-related eosinopenia is due to both decreased release of eosinophils from the bone marrow and glucocorticoid-potentiated apoptosis. Because there are relatively few eosinophils in the blood of healthy patients, it is often difficult to recognize eosinopenia in a clinical setting.3
Monocytosis is most commonly associated with the corticosteroid/stress leukogram in dogs, variably found in other species, and likely the result of monocytes moving from the marginating to circulating pool; however, monocytosis is incompletely understood.1
Over time, the magnitude of neutrophilia decreases, but lymphopenia and eosinopenia persist while plasma corticosteroid concentrations remain increased.3
Hypersegmented neutrophil (dashed arrow) on the blood film of an apparently healthy dog. The inset shows nuclear segments (1-6) and fine nuclear filaments between some lobes (arrows). Modified Wright’s stain, 1000× magnification
2. Acute Inflammatory Leukogram
An acute inflammatory leukogram pattern has leukocytosis due to neutrophilia with a left shift, lymphopenia, and/or monocytosis (Table 2).1
Recognition of a significant left shift is key to identify this pattern and an indicator that the stimulus for release of neutrophils from bone marrow is greater than that which can be fulfilled by the neutrophil storage pool (which only comprises mature neutrophils).3 In this context, acute refers to the type, not the duration, of inflammation.1 An acute inflammatory leukogram pattern may be seen when there is an active need for neutrophils and bone marrow has not caught up to tissue demand.1
Release of band neutrophils, metamyelocytes (potentially), and myelocytes (less commonly) from the maturation pool is the hallmark of the acute inflammatory leukogram.1,4,5 An acute inflammatory leukogram is expected during significant inflammation of internal or subcutaneous tissues due to infectious or noninfectious diseases.3,4 Cytokines from the inflammatory site stimulate bone marrow to increase the release of neutrophils from storage and maturation pools and increase neutrophil production.
Acute Inflammatory Leukogram In A Dog*
*Characterized by leukocytosis due to neutrophilia with a left shift and toxic changes, lymphopenia, and monocytosis
†Values outside the reference intervals are bold.
‡Percentage of cells identified on manual WBC differential; value used to calculate the absolute concentration (displayed in the result column)
Hematology analyzers do not differentiate between mature (segmented) and immature neutrophils; therefore, blood film examination is necessary for identification of band neutrophils and other immature neutrophils.6,7 Toxic changes of neutrophils (eg, Döhle bodies, increased cytoplasmic basophilia, foamy/vacuolated cytoplasm, retained primary granules) are also common and indicate accelerated production of neutrophils (Figure 3).1,6,7
Lymphopenia occurs after release of inflammatory cytokines3 and is the result of increased migration of lymphocytes to inflamed tissues, movement of lymphocytes to lymphoid tissue, and decreased migration of lymphocytes from lymphoid tissue back into circulation.1
Monocytosis is a possible result of cytokine stimulation.1,3
Blood film from a dog with peritonitis. Band neutrophils (1 and 2) exhibit toxic changes (ie, Döhle bodies [arrows], increased cytoplasmic basophilia) that indicate accelerated production of neutrophils.1 Modified Wright’s stain, 1000× magnification
Blood film from a dog with heartworm disease showing a reactive lymphocyte (arrow, inset) with increased size (approximately the same size as a neutrophil), increased cytoplasmic basophilia, and a convoluted nucleus. Modified Wright’s stain, 1000× magnification
3. Chronic Inflammatory Leukogram
A chronic inflammatory leukogram has mature neutrophilia with minimal or no left shift, lymphocytosis, and monocytosis (Table 3).1 This pattern occurs when the inflammatory stimulus has been present for a minimum of one week and is associated with development of granulocytic hyperplasia, resulting in bone marrow meeting the demand of neutrophil consumption within tissues.1 No, or minimal, left shift is present because granulocytic hyperplasia is able to maintain the storage neutrophil pool. Characteristic lymphocytosis is secondary to antigenic stimulation due to increased lymphopoiesis. Reactive lymphocytes are common (Figure 4).1
In leukogram patterns, acute refers to the type of inflammation, not the duration of the inflammatory stimulus. Although a chronic inflammatory leukogram consistently takes at least one week to develop, the pattern may never be reached if the inflammatory stimulus is intense, even with granulocytic hyperplasia, as bone marrow may not meet the demand, and a significant left shift can persist.1
Chronic Inflammatory Leukogram In A Dog With Chronic Pyoderma*
*Characterized by leukocytosis with a mature neutrophilia, lymphocytosis including reactive lymphocytes, and monocytosis
†Values outside the reference intervals are bold.
‡Percentage of cells identified on manual WBC differential; value used to calculate the absolute concentration (displayed in the result column)
4. Acute, Severe, Overwhelming Inflammatory Leukogram
The acute, severe, overwhelming inflammatory leukogram, characterized by neutropenia with a left shift and lymphopenia (Table 4),1 is similar to the acute inflammatory leukogram in mechanism; however, neutropenia can result when cytokine-stimulated emigration of neutrophils to inflamed tissue exceeds the rate of neutrophil release from bone marrow. Neutrophils released from bone marrow are frequently immature and exhibit evidence of toxic change (Figure 3).1,8 Endotoxin-mediated sequestration of neutrophils in the marginating pool (and thus a shift of neutrophils out of the circulating pool) may play a significant role in patients with endotoxemia.9
Acute, Severe, Overwhelming Inflammatory Leukogram In A Cat With Pyothorax*
*Characterized by leukopenia due to neutropenia with a degenerative left shift and toxic changes and lymphopenia
†Values outside the reference intervals are bold.
‡Percentage of cells identified on manual WBC differential; value used to calculate the absolute concentration (displayed in the result column)
5. Physiologic/Excitement Leukogram
A physiologic/excitement leukogram comprises leukocytosis due to mature neutrophilia, lymphocytosis, and/or monocytosis (Table 5) and develops rapidly following adrenal release of catecholamines (eg, epinephrine, norepinephrine).1,3,8 This pattern occurs primarily in cats, horses, and young dogs (occasionally) following fear (ie, fight or flight response), excitement, or exercise.
Catecholamines stimulate a shifting of neutrophils, lymphocytes, and/or monocytes from the marginating to circulating pool, likely secondary to a change in fluid dynamics and resulting in increased blood flow rate through microcirculation.1
Morphologic changes of neutrophils and lymphocytes are not expected, and there is no left shift. A leukocytosis 4 times greater than the upper reference limit is possible because the marginating neutrophil pool in cats is ≈3 times larger than the circulating pool,1,3 although this is rare in the authors’ experience.
The catecholamine response—and the leukogram pattern as a whole—is transient; the leukogram should return to normal within 30 minutes after the stimulus is removed.3 Although patient history of being clinically healthy but frightened should help identify this response, the authors suggest resampling the blood after the patient has calmed (or is sedated) to confirm whether a physiologic/excitement response is the cause of leukocytosis.
Physiologic/excitement Leukogram In A Fearful Cat*
*Characterized by leukocytosis due to a mature neutrophilia, no left shift, lymphocytosis, and monocytosis
†Values outside the reference intervals are bold.
‡Percentage of cells identified on manual WBC differential; value used to calculate the absolute concentration (displayed in the result column)